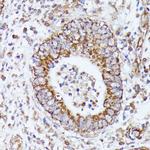
DLAT Antibody in Immunohistochemistry (Paraffin) (IHC (P))

Search
Invitrogen
DLAT Polyclonal Antibody
{{$productOrderCtrl.translations['antibody.pdp.commerceCard.promotion.promotions']}}
{{$productOrderCtrl.translations['antibody.pdp.commerceCard.promotion.viewpromo']}}
{{$productOrderCtrl.translations['antibody.pdp.commerceCard.promotion.promocode']}}: {{promo.promoCode}} {{promo.promoTitle}} {{promo.promoDescription}}. {{$productOrderCtrl.translations['antibody.pdp.commerceCard.promotion.learnmore']}}

Please note: We are reviewing Western blot images included in the antibody testing data in our catalog, including those provided by third parties. Unless expressly labeled or annotated as “raw-unedited”, Western blot images included in the antibody testing data in our catalog may have been edited, optimized or otherwise adjusted for presentation.
产品信息
PA5-120279
种属反应
宿主/亚型
分类
类型
抗原
偶联物
形式
浓度
规格
纯化类型
保存液
内含物
保存条件
运输条件
RRID
产品详细信息
Positive test controls include: HeLa, MCF7, HepG2, K-562, Mouse brain, Rat brain. The target is usually found in the following locations: Mitochondrion matrix.
Immunogen sequence: SLPPHQKVPL PSLSPTMQAG TIARWEKKEG DKINEGDLIA EVETDKATVG FESLEECYMA KILVAEGTRD VPIGAIICIT VGKPEDIEAF KNYTLDSSAA PTPQAAPAPT PAATASPPTP SAQAPGSSYP PHMQVLLPAL SPTMTMGTVQ RWEKKVGEKL SEGDLLAEIE TDKATIGFEV QEEG
靶标信息
DLAT encodes component E2 of the multi-enzyme pyruvate dehydrogenase complex (PDC). PDC resides in the inner mitochondrial membrane and catalyzes the conversion of pyruvate to acetyl coenzyme A. The protein product of this gene, dihydrolipoamide acetyltransferase, accepts acetyl groups formed by the oxidative decarboxylation of pyruvate and transfers them to coenzyme A. Dihydrolipoamide acetyltransferase is the antigen for antimitochondrial antibodies. These autoantibodies are present in nearly 95% of patients with the autoimmune liver disease primary biliary cirrhosis (PBC). In PBC, activated T lymphocytes attack and destroy epithelial cells in the bile duct where this protein is abnormally distributed and overexpressed. PBC eventually leads to cirrhosis and liver failure.
仅用于科研。不用于诊断过程。未经明确授权不得转售。
篇参考文献 (0)
生物信息学
蛋白别名: 70 kDa mitochondrial autoantigen of primary biliary cirrhosis; anti DLAT; Dihydrolipoamide; Dihydrolipoamide acetyltransferase component of pyruvate dehydrogenase complex; dihydrolipoamide S-acetyltransferase (E2 component of pyruvate dehydrogenase complex); Dihydrolipoyllysine-residue acetyltransferase component of pyruvate dehydrogenase complex, mitochondrial; E2; EC 2.3.1.12; M2 antigen complex 70 kDa subunit; ODP2; PBC; PDC PDC-E2; PDC-E2; PDCE2; Pyruvate dehydrogenase complex component E2
基因别名: 6332404G05Rik; DLAT; DLTA; PDC-E2
UniProt ID: (Rat) P08461, (Mouse) Q8BMF4
Entrez Gene ID: (Rat) 81654, (Mouse) 235339




